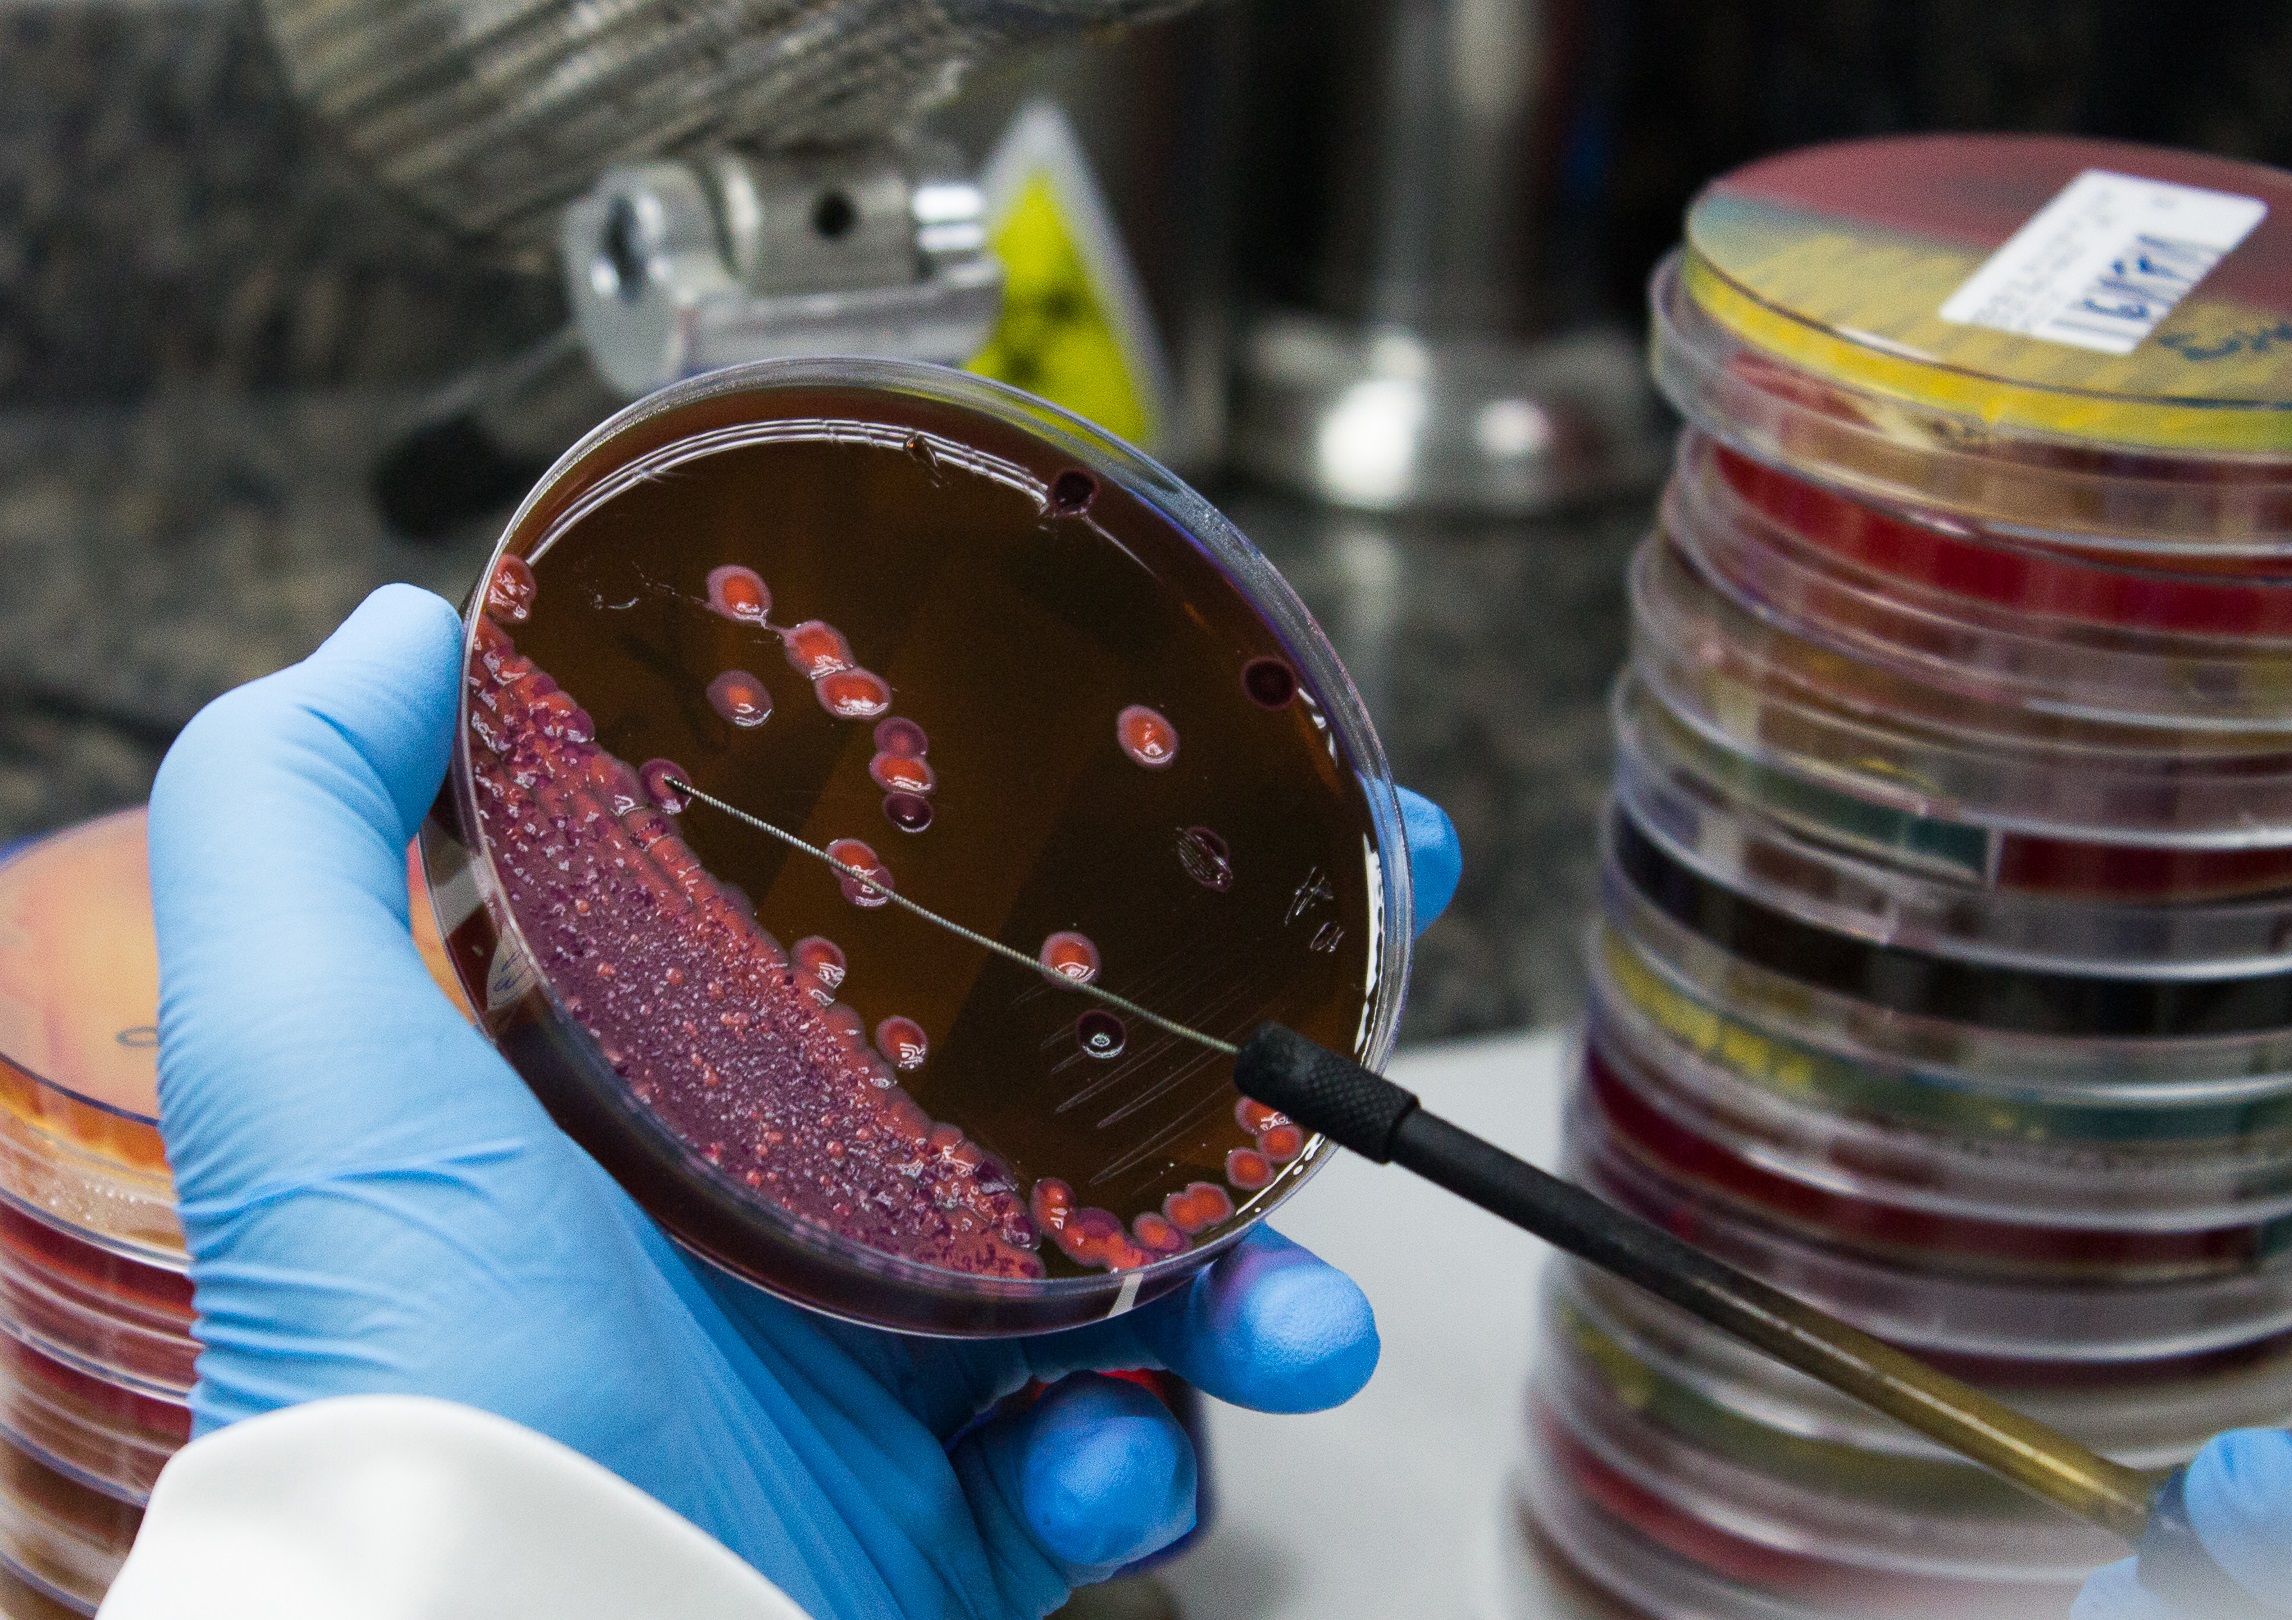

Discover the true potential of your data with our data science experts and machine learning.
Discover the true potential of your data with our data science experts and machine learning.
Discover the true potential of your data with our data science experts and machine learning.
Contáctanos
Error: Formulario de contacto no encontrado.